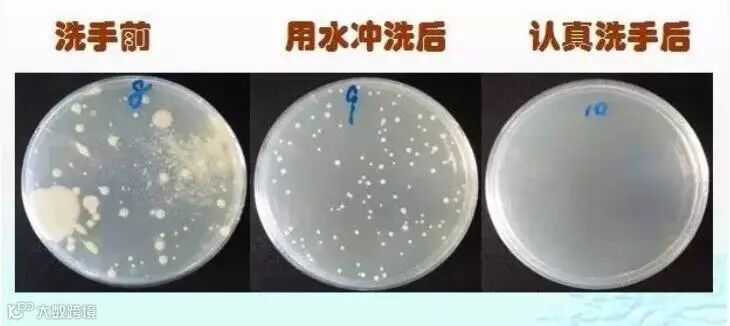

我们都知道,饭前便后要洗手,可是你真的会洗手吗?我们来随机采访一下各位街坊。


洗手很简单啦,用水冲一下就好~
用肥皂或洗手液搓两下,冲水就可以啦!




我习惯用脸盆盛水洗手~
要用流动的清水洗,洗完把手甩干




打开水龙头,洗个10秒8秒,搞定!
果然,很多人都
不!会!洗!手!
洗/手/的/重/要/性
我们的双手每天要跟成千上万的细菌、病毒等微生物亲密接触。微生物学家塔莎-斯特姆(Tasha Sturm)通过实验,在培养皿上发现8岁儿子手掌上的大量细菌。

正常情况下,肥皂(或洗手液)洗手可预防感染性腹泻、流感、手足口病、红眼病等多种传染病,掌握正确的洗手方法,养成良好的洗手习惯,是保持饮食卫生,预防传染病最简单、经济的方法。
当下进入秋冬季节是呼吸道和肠道传染病的高发季节,通过洗手可以有效预防这些疾病的发生哦!

何/时/洗/手/要/谨/记
做这些事之前
准备食物前、吃饭前、戴隐形眼镜、给伤口涂药、照顾病人、抱孩子等。
做这些事之后
使用厕所,擦鼻涕、咳嗽或打喷嚏,接触钱币,换尿片,照顾病人,接触呕吐物或清理粪便,处理未熟的食物,处理伤口,处理垃圾,使用公共交通工具或设施,外出回到家等。

如/何/正/确/洗/手?
请戳以下视频,看看你的洗手方法是否正确。
看完视频,再来回顾一下正确洗手的关键步骤:
湿
用清水把双手淋湿
搓
用肥皂或洗手液,将手心、手臂、指缝相对搓揉20秒(大概唱2遍生日歌旋律的时间)

冲
用清水把手冲洗干净
捧
捧水冲洗水龙头并关紧
擦
用干净的毛巾/一次性纸巾擦干

整个洗手过程,至少洗够30秒而不是10秒8秒就完事哦~

误区一:用盆盛水洗手
不少老人习惯用脸盆盛水洗手,如果盆里的水已弄脏了,用脏水洗手,手仍然是脏的,这样是达不到去除手中病菌的目的。如果几个人在同一盆水中洗手,不仅起不到除菌的效果,甚至还可能带来交叉感染。一定要用流动的水冲洗!
误区二:只用清水,不用肥皂/洗手液洗手
清水洗手远远不足以洗去细菌,看看下图就知道了!使用肥皂或洗手液才能有效去除油脂、污垢和病菌。
△ 洗手前、用水冲洗后和认真洗手后的手部菌落图
值得注意的是,居家使用肥皂应及时清洗肥皂盒,保持干燥,如果盒底不能保持干燥,潮湿的环境下也会滋生细菌。而使用洗手液可以在每次按压后取得一定的量,较少反复触摸被污染的问题。
养成良好洗手习惯
学会正确洗手方法
才能“手”护健康!
文章来源于广州市健康教育所,如有侵权,请联系删除!


